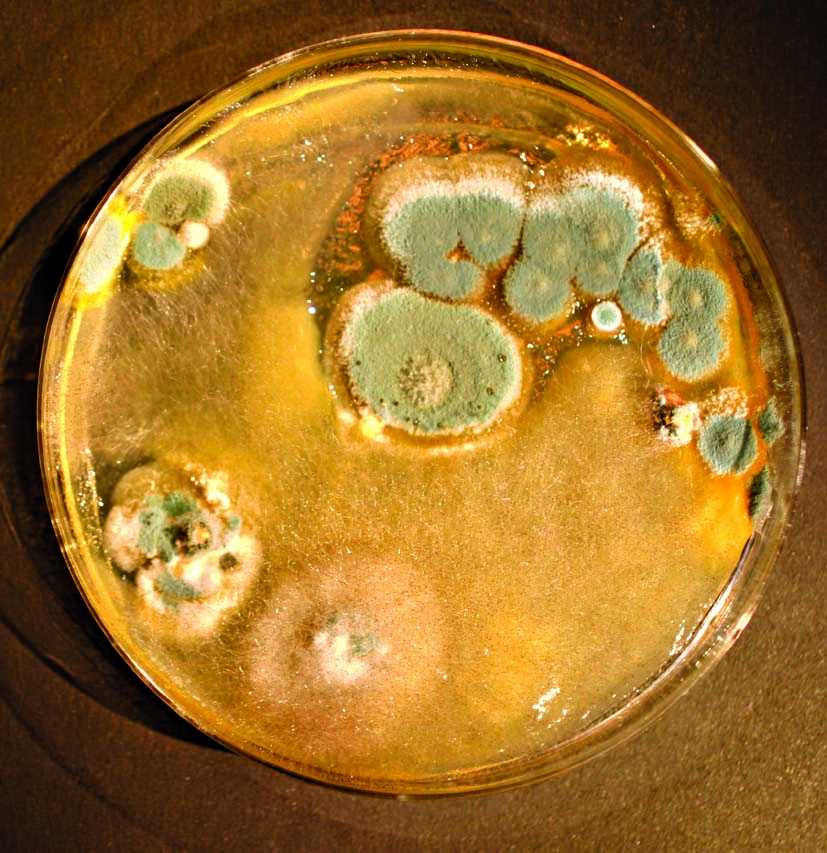

Science Klubben er et tilbud til NaturBornholms venner i alderen 10-15 år.
Her får børn og unge mulighed for at fordybe sig i emner om natur og geologi gennem aktiviteter og eksperimenter, som imødekommer de unges nysgerrighed og interesse!
Praktisk info:
Mødested nævnes ikke, når arrangementer er på NaturBornholm.
Medlemskabet giver:
- Fri adgang hele sæsonen med forældre eller bedsteforældre*
- Adgang til aktiviteter og arrangementer i løbet af året.
- Invitation til forpremiere på årets nyheder
- Et medlemskort med foto
*Et medlemskab i Science Klubben gælder for ét barn. Medlemskortet giver adgang til NaturBornholm for 4 personer inklusiv de(n) på kortet angivne. Der tages et foto og udstedes et medlemskort ved første besøg på NaturBornholm.
Medlemskab af ‘NaturBornholms venner med ledsager’ giver også adgang til NaturKlubbens aktiviteter. Køb det her
Dette års program:
10. januar kl. 10-12
Huden giver dyr superkræfter
Over millioner af år har huden udviklet sig til meget mere end et hylster, der holder organerne på plads. Den kan ånde, køle ned, lave fotosyntese, opspore byttedyr, skaffe vaske og beskytte. Kom helt tæt på slanger og andre levende dyr, og mærk med fingrene deres hud eller skjold. Vi undersøger også pels, uld, fjer og skæl i stereolup og mikroskop.
31. januar kl. 10-12
Parasitter
Sammen med professor i akvatisk patobiologi Kurt Buchmann dykker vi ned i parasitternes verden. Vi dissekerer fisk, leder efter parasitter i muskler og indvolde og taler om, hvordan de påvirker livet i Østersøen.
Book plads her
21. marts kl. 10 – 12
Byg en fiskebørnehave
En fiskebørnehave er som insekthotel - bare i vand. Den giver små dyr og fiskeyngel et trygt sted at gemme sig og finde mad, indtil de kan klare sig selv. Kom og vær med til at skabe mere liv i Bornholms havne.
Mødested: Mødested: Nexø Vodbinderi, Sdr Hammer 33, 3730 Nexø
Book plads her:
19. april kl. 10 - 16
Prøv NaturKlubben og Science Klub gratis
Vil I være med i ScienceKlubben? Besøg NaturBornholm og prøv klubben gratis. Kom tæt på levende dyr, sav en sten over og bag boller på bål. Vi laver også forskellige science eksperimenter. Oplev naturens forunderlige verden og mød nye venner at være nysgerrige sammen med.
Book plads her:
16. maj kl. 13-15
Zoom ind på edderkopperne og andre spindlere
Kom med ind i edderkoppernes fascinerende verden. Oplev deres mange farver, former og størrelser. Vi går på jagt efter edderkopper og deres smukke spind. Vi taler også om de små superhelte fra naturen og om andre spindler – skovflor, Danmarks farligste dyr.
20. juni kl. 13 - 15
Gro din madpakke
Mange af de grøntsager, I har i køkkenet, kan gendyrkes. Kom og prøv det selv. Vi laver også science eksperimenter med planter, naturens superhelte og viser hvordan fotosyntese fungerer. Aktiviteten slutter af med vild mad over bål.
22. august kl. 10 - 15
En tur til Christiansø
Vi tager på ekspedition for at undersøge Ertholmenes unikke natur – planter, laver, fugle, sæler og insekter. Sammen med naturvejlederen fra Naturpark Christiansø deltager vi i kortlægningen af øernes smådyrsliv.
Mødested: Gudhjem Havn, Ejnar Mikkelsensvej 25, 3760 Gudhjem
12. september kl. 20 – 22
Flagermus og Natsværmer
Kom med på en stemningsfuld aftentur i den flotte natur i Rø Plantage. Vi skal ud i mørket og opleve en masse af nattens dyr. Morten Top Jensen lokker natsværmere frem med sukker og lys, og Kenneth Nielsen viser os, hvordan man bruger flagermusdetektorer til at høre og se flagermus.
Mødested: Rø Plantage, P-plads Sigtevej 2, 3760 Gudhjem
3. oktober kl. 10 – 12
Science eksperimenter i laboratoriet
I vores laboratorie bevæger vi os ind i kemiens verden. Vi skal prøve at lave vores egen bioplast og andre kemiske forsøg sammen med Bornholms unge kemitalent Yoko Froholdt.
7. november kl. 10 – 12
Svampenes hemmelige verden.
Svampe er fascinerende. De kan være mikroskopisk små eller brede sig over 9 km2. De findes i skoven, i huset, i maden – ja selv endda i din egen krop! Kom og udforsk svampenes forunderlige verden. Under stereolup og mikroskop undersøger vi små svampe og laver. Vi taler også om, hvad svampe betyder for naturen og hvordan de bruges i medicin, kosmetik, madlavning og byggeri.